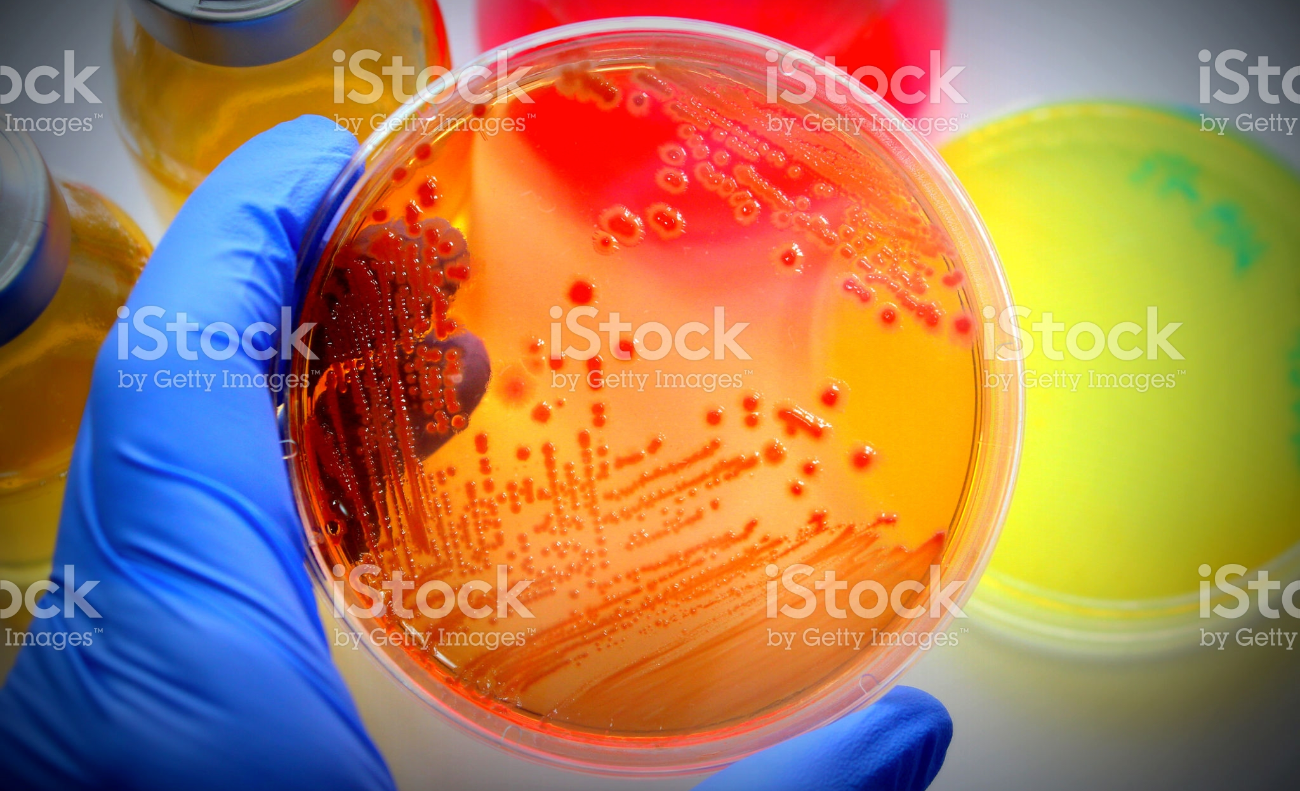
Screen Shot 2016-09-10 at 11.48.43 AM.png

TESTING SERVICES AND CUSTOM PROGRAMS
We specialize in creating programs that help keep patients "in the middle" of their paths to recovery.
Unlike other companies, Resolve Diagnostics focuses on testing solutions for the recovery community.
We partner with programs, institutions, and recovery centers across the USA to build plans that improve patient outcomes and restore people to sober, meaningful lives.
Coding
G0479
G0480
G0481
G0482
G0483
treatment plan recommendations
Resolve Diagnostics reviews of adjudicated claims reveals that staying "in the middle "of the codes G0480-G0483 generates fewer denials and medical records requests.
Intensive outpatient program/partial hospitalization program
(IOP/PHP)
1-6 Weeks
Codes G0479 and G0482
2x/week
7-10 Weeks
Codes G0479 and G0480
1x/week
11+ Weeks
G0479 reflex
to confirm any inconsistencies and positives
2x/week
Recommended inpatient program
Duration of inpatient treatment
G0479 reflex
to confirm any inconsistencies and positives and auto confirm drug of choice
Testing and Diagnostic codes
G0479 Drug tests, presumptive
Any number of drug classes; any number of devices or procedures by instrumented chemistry analyzers
- Immunoassay
- Enzyme assay
- TOF
- MALDI
- LDTD
- DESI
- DART
- GHPC
- GC mass spectrometry
Includes sample validation when performed, per date of service
G0480 Drug tests, definitive
Drug identification methods to identify individual drugs and distinguish between structural isomers (but not necessarily stereoisomers), including, but not limited to
- GC/MS (any type, single or tandem)
- LC/MS (any type, single or tandem and excluding immunoassays (IA, EIA, ELISA, EMIT, FPIA)
- Enzymatic methods (eg, alcohol dehydrogenase)
Qualitative or quantitative, all sources, includes specimen validity testing, per day, 1-7 drug class(es), including metabolites if performed.
G0481 Drug tests
Includes specimen validity testing, per day, 8-14 drug classes including metabolites if performed.
G0482 Drug tests
Includes specimen validity testing, per day, 15-21 drug classes including metabolites if performed.
G0483 Drug tests
Includes specimen validity testing, per day, 22 or more drug classes including metabolites if performed.